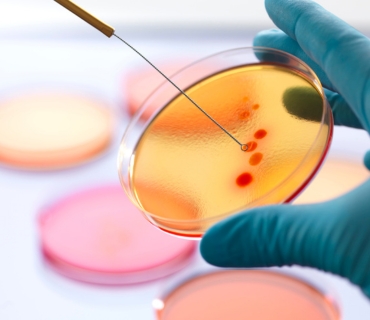

Our Services
Clinical laboratory services are tests provided by a medical lab that aid in diagnosis and treatment of patients. There are many types of clinical laboratory services, including:
Hematology
Laboratory Services provides an expanding menu of Hematology. Our services include:
- Complete Blood Count (CBC)
- Coagulation Profile
- Hemoglobin Electrophoresis
- Peripheral Blood Smear
- Bone Marrow Aspiration and Biopsy
- Reticulocyte Count
Microbiology
Our SANAS accredited microbiology laboratory provides diagnostic services to both the private and public sectors.
- Bacterial Culture and Sensitivity Testing
- Fungal Culture
- Viral PCR Testing
- Parasitological Examination
- Antibiotic Susceptibility Testing
- Microbial Identification
Histopathology
We are an industry leader in ensuring exceptional quality testing in our state-of-the-art Histopathology facilities.
- Tissue Biopsy Analysis
- Immunohistochemistry (IHC)
- Frozen Section Analysis
- Special Stains
- Electron Microscopy
- Consultation Services
Clinical pathology
Clinical Pathology offers an extensive range of diagnostic testing services crucial for understanding and diagnosing diseases.
- Complete Blood Count (CBC)
- Basic Metabolic Panel (BMP)
- Comprehensive Metabolic Panel (CMP)
- Liver Function Tests (LFTs)
- Renal Function Tests (RFTs)
- Thyroid Function Tests (TFTs)s
Virology
Virology explores viruses, their structure, behavior, and impact on health, aiding in understanding and fighting viral infections.
- Viral Culture
- Viral Load Testing
- Serology
- PCR Testing
- Antigen Testing
- Genotyping
Blood Bank
Lifesaving hub for blood donation, storage, and distribution, supporting critical medical interventions.
- Blood Typing
- Crossmatching
- Quality Control
- Antibody Screening
- Infectious Disease Testing
- Blood Component Preparation
Molecular Testing & Oncology
Laboratory Services provides an expanding menu of molecular-based testing. Our services include:
- Chemotherapy
- Hormone therapy
- Immunotherapy
- Precision genomics
- Radiation oncology
- Surgical oncology
Histology
Our SANAS accredited histology laboratory offers a diagnostic service to both the private and public sectors.
- Immunocytochemistry
- Immunofluorescence
- Electron Microscopy
- Neuropathology
- Muscle biopsies
- Nerve biopsies
General Diagnostic Tests
We are an industry leader in ensuring exceptional quality testing in our state-of-the-art facilities.
- Complete blood counts
- Anticoagulant Therapy Monitoring
- Blood Chemistry Analyses
- Therapeutic drug monitoring
- Microbiology
- Urinalysis
Naturopathic Tests
We will perform both standard and specialized naturopathic lab tests as part of the assessment process.
- Gastrointestinal Testing
- Laboratory Tests on Hormonal Levels
- Cardiovascular Lab Tests
- Toxins & Pollutant Testing
Genetics Tests
Genetic testing can deliver much more than ancestry information for the curious. Genetic testing is a medical laboratory test that examines into your genes.
- PCR
- DNA Sequencing
- Cytogenetics (Karyotyping and FISH)
- Microarrays
- Gene Expression Profiling
Cytology
The purpose of a cytological examination is generally for the cytological detection of malignancy.
- Gynaecological Cytology
- Non-Gynaecological Cytology
- Fine Needle Aspiration Cytology
- BAL Differential Cell Count
- Sputum Cell Count
- Urine Cytology
Sexual Health Screening
Having a sexual health screen can be a positive thing to do if you're sexually active or you've had unprotected sex.
- Female Basic screen without bloods
- Male Basic screen
- STI Male Standard Screen
- Vaginitis / BV Profile
- STI Complete Screen
- Hepatitis C Profile
Infection Screening
If you have the virus, finding out quickly means you can start treatment right away so you can live a long, full life.
- Antenatal infection
- Hepatitis Screening
- HIV
- Chlamydia
- Tropical Screen
- Tuberculosis, TB
Infection Screening
If you have the virus, finding out quickly means you can start treatment right away so you can live a long, full life.
- Antenatal infection
- Hepatitis Screening
- HIV
- Chlamydia
- Tropical Screen
- Tuberculosis, TB
Endocrinology
Investigating hormones and their impact on health and disease management.
- Thyroid Function Tests
- HbA1c
- Cortisol Testing
- Insulin Assays
- Testosterone Assays
- Parathyroid Hormone (PTH) Testing